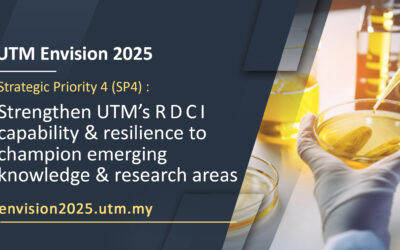
UTM Envision 2025 : SP 4

Cover Photo/Header
A centralized repository for official design materials, visual assets, and creative resources to ensure consistency and quality across all communications.
SISPAA
QS World University Ranking
Header emel rasmi Pusat Komunikasi Korporat
Eid Mubarak
Ramadan 1446H
Cover photo Facebook NC
Cover Photo FB New Year 2025
Email Header & Footer for web Gratitude Email 2024
UTM Envision 2025 : SP 6
UTM Envision 2025 : SP 5
64th Malaysia National Day
UTM Envision 2025 : SP 4
PPV IPT Integrasi UTM
UTM Envision 2025 : SP 3
UTM Envision 2025 : SP 2
UTM Envision 2025 : SP1
Eid Mubarak 1442H
RAMADAN KAREEM
September 2021 intake is now open
Staf Safe, Stay in Campus, Stay Focused
UTM Robotics
UTM Virtual Postgraduate Open Day 2021
New Year 2021
Februari 2020 Intake
Our Experts
Happy New Semester
UTM virtual career carnival 2020
Global Connection
Happy Malaysia Day
UTM Open Day
63rd National Day
Zero Waste
UTMSpace Virtual Open Day 2020
RANKED #187 in QS World Ranking
Breaking the 200th mark in the QS World University Rankings 2021. Committed to excellence.
RESEARCH IN UTM
Our researchers share practical ideas and expertise to tackle global challenges and help solve community problems.
EID MUBARAK
Wishing you and your loved ones a blessed Eid #stayathome
RAMADAN
May the spirit of Ramadan remain in our hearts and light up our souls from within. Have a blessed Ramadan. Ramadan Kareem.
A BIG THANK YOU
To our heroes and heroines,The frontliners.
BEST GLOBAL UNIVERSITY FOR ENGINEERING
UTM is ranked #40 in the Best Global Universities for Engineering by the U.S. News & World Report